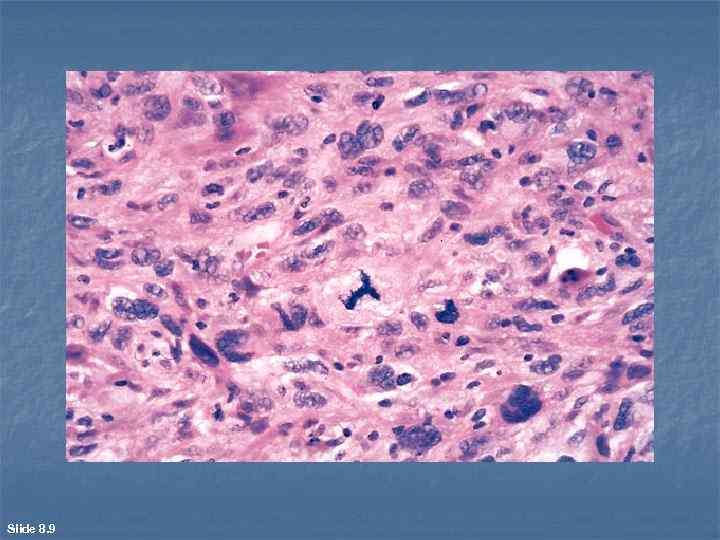

9-ОПУХОЛИ 3 курс.ppt
- Количество слайдов: 41

ОПУХОЛИ

Опухоль (новообразование, тумор, неоплазма, бластома) это патологический процесс илисубстрат, представленный новообразованной тканью, в которой изменения генетического аппарата клеток приводят к нарушению регуляции их роста и дифференцировки.

Slide 8. 12

Slide 8. 14

Slide 8. 20

Факторы риска развития опухолей n Выделяют группы важнейших факторов риска, способствующих возникновению доброкачественных и злокачественных новообразований. 1. Старение. По мере старения может увеличиваться количество невусов ("родимых пятен"), иногда возникают базально клеточные папилломы кожи ("старческие бородавки"). Люди старше 55 лет вступают в тот период жизни, когда с каждым годом прогрессивно повышается возможность появления злокачественной опухоли. Больше всего случаев смерти от злокачественных новообразований отмечают в возрастном интервале от 55 до 74 лет. 2. Влияние географических зон и факторов окружающей среды. Существуют значительные географические различия в показателях заболеваемости и смертности от злокачественных опухолей: смертность от рака желудка в Японии выше, чем в США, в 7 8 раз, а смертность от рака легкого, наоборот, в 2 раза выше в США, чем в Японии; по сравнению с Исландией меланомы кожи встречаются и приводят к смерти в Новой Зеландии в 6 раз чаще; n из факторов окружающей среды следует назвать ультрафиолетовое облучение (солнечную радиацию); определенный образ жизни людей, например курение, алкоголизм, особенности питания и превышение массы тела на 25 % от средней конституциональной нормы; большое число половых партнеров, особенно при раннем начале половой жизни.

3. Наследственность. 5 10 % злокачественных опухолей человека связаны с наследственной предрасположенностью. Смертность от рака легкого среди некурящих ближайших родственников лиц, умерших именно от этого заболевания, в 4 раза выше, чем у некурящих родственников людей, погибших от других болезней. n Наследуемые формы злокачественных новообразований разделяют на 3 группы: 1) наследственные опухолевые синдромы; 2) семейные формы неоплазии; 3) аутосомно рецессивные синдромы нарушенной репарации ДНК. Наследственные опухолевые синдромы. n К этой группе относятся новообразования, при которых наследование единственного мутантного гена значительно повышает риск их развития. Такая предрасположенность относится к аутосомно доминантному типу наследования. Самый частый пример из этой группы ретинобластома (злокачественная нейроэпителиома сетчатки), сочетающаяся у детей остеосаркомой или аденоматозным полипозом толстой кишки. При каждом из синдромов опухолевый процесс затрагивает весьма определенную органную и тканевую локализацию.

n n n Так, синдром множественной эндокринной неоплазии (МЭН) типа 2 касается лишь поражений щитовидной железы, околощитовидных желез и надпочечников. В этом случае отмечаются неполная пенетрантность (частота или вероятность проявления гена) и различная экспрессивность (степень развития признака) гена. Семейные формы неоплазии Многие распространенные типы злокачественных опухолей встречаются в семейных формах: карцинома кишки, молочной железы, яичников, опухоли головного мозга. Общими признаками семейной неоплазии являются возникновение в раннем возрасте, появление минимум у двух, а то и большего числа ближайших родственников, частое формирование двусторонних или множественных поражений. Семейным формам не свойственны ни характерный фенотип, ни специфическая динамика. Аутосомно – рецессивные синдромы нарушенной репарации ДНК Речь идет о нестабильности структуры ДНК или хромосом при пигментной ксеродерме (проявляющейся в пигментации, гиперкератозе, отеке и других изменениях кожи при солнечном облучении), анемии Фанкони (характеризующейся гипоплазией костного мозга, низким содержанием клеток крови, многими аномалиями).

4. Хронические nролиферативные изменения. n n n Основой для малигнизации служат метаболические, дисгормональные и хронические воспалительные процессы: очаговая гиперплазия, метаплазия и дисплазия эпителия бронхов, возникающие у курильщиков; гиперплазия, дисплазия, а также нарушения дифференцировки в выстилке влагалищной порции шейки матки, имеющие дисгормональную природу; хроническая язва желудка, цирроз печени.

В основе канцерогенеза лежат нелетальные повреждения генетического аппарата (генома) клеток мутации: генные, при которых изменяется число или последовательность мононуклеотидов в пределах одного гена, или геномные, при которых изменяется число хромосом или их наборов. Указанные повреждения генома в соматических клетках могут быть приобретенными вследствие воздействия факторов окружающей среды: - химических канцерогенных веществ (полициклических углеводородов, ароматических аминов, нитрозаминов); - радиации (ультрафиолетовой, ионизирующей); - вирусов ДНК содержащих (вирусов папилломы человека, возбудителей гепатитов В и С, Эпштейна Барри), ретровирусов (лимфотропного вируса человека, НТLV l). n

n n Генетическая концепция канцерогенеза подразумевает, что популяция опухолевых клеток это результат размножения, "идущего" от одной клетки родоначальницы клона, претерпевшей опухолевую трансформацию. В этом заключается смысл представления о моноклональном развитии опухолей. Основными мишенями для генетического воздействия при опухолевой трансформации служат два класса нормальных регуляторных генов: протоонкогены - промоторы (активаторы) роста клеток и канцеросупрессорные гены (антионкогены), тормозящие рост клеток. Протоонкогены нормальных клеток, обычно находятся в неактивном состоянии. При активации они превращаются в онкогены, которые кодируют определенные онкобелки. При этом происходят опухолевая трансформация и пролиферация клеток. Мутантные аллели (измененные состояния) протоонкогенов расценивают как доминантные (преобладающие и препятствующие появлению других состояний), поскольку они трансформируют клетки, несмотря на наличие их нормальных копий. В противоположность этому обе нормальные аллели антионкогенов должны быть повреждены для того, чтобы осуществилась трансформация. В связи с этим семейство генов (Rb, р53 и др. ) иногда относят к рецессивным онкогенам (проявляющимся в гомозиготном состоянии, т. е. при наличии двух своих идентичных аллелей). К 3 му классу генов, тоже имеющих важное значение в канцерогенезе, относят гены, контролирующие запрограммированную гибель клеток (апоптоз).

Канцерогенез стадийный, многоступенчатый процесс как на генетическом (инициация), так и на фенотипическом (промоция) уровнях. Этот фенотип у злокачественных опухолей обладает несколькими свойствами способностью к избыточному росту, инвазии и метастазированию. Данные свойства при обретаются в ходе прогрессии опухоли, т. е. постепенных изменений ее фенотипа, направленных обычно в сторону наращивания злокачественности.

Номенклатура и классификации Главный принцип обозначения опухолей: в качестве корня слова используется название ткани, реже органа (или его части), к которому добавляется суффикс "ома". Примеры: липома, фиброма, ангиома, гепатома, менингиома. Важнейшие исключения из этого принципа: карцинома – злокачественная опухоль из эпителиальной ткани, саркома – злокачественная опухоль из не эпителиальной ткани (канцер понятие, суммарно обозначающее злокачественную опухоль вообще), лейкозы злокачественные опухоли кроветворной системы, лимфомы злокачественные опухоли иммунной системы. n Традиционная клинико - морфологическая классификация подразделяет все новообразования на два важнейших класса: доброкачественные и злокачественные.

Доброкачественные опухоли n n n n растут экспансивно, раздвигая и сдавливая окружающие ткани; четко ограничены и могут иметь фиброзную капсулу; в полых и трубчатых органах характеризуются экзофитным типом роста (растут в просвет); почти всегда растут медленно; не дают метастазов; обладают тканевым атипизмом, но не имеют атипии и полиморфизма клеток опухолевой паренхимы; характеризуются митотической активностью опухолевой паренхимы, редко выходящей за пределы соответствующей нормы.

Злокачественные опухоли n n n обладают инвазивным (инфильтрирующим) ростом с прорастанием окружающих тканей и их разрушением; в полых и трубчатых органах характеризуются эндофитным типом роста (растут в толщу стенки органа); почти всегда растут быстро; часто дают метастазы; обладают тканевым атипизмом, а также атипизмом и полиморфизмом клеток опухолевой паренхимы (отличиями этих клеток от нормальных аналогов и отличиями между собой по расположению, величине, форме и степени окраски); часто характеризуются повышенной митотической активностью опухолевой паренхимы и наличием зон некроза.

Slide 8. 8
Slide 8. 9

Важными в клиническом и прогностическом отношении являются гистологическая градация злокачественных новообразований по степени дифференцировки пapeнxuмы. По уровню гистологической дифференцировки выделяют: n высокодифференцированные опухоли (степень G 1). Обладают паренхимой, которая по строению и функции ближе всего к своему нормальному аналогу. Клеточный атипизм и полиморфизм в них выражены слабо. Склонность к росту, инвазии и метастазированию не достигает максимального уровня; n умереннодифференцированные опухоли (степень G 2). Указанные показатели выражены сильнее, степень злокачественности выше; n низкодифференцированные опухоли (степень G 3). Признаки, перечисленные выше, выражены особенно сильно.

Система TNM классификация, отражающая стадии прорастания и распространения опухоли. Буквой Т (tumor) обозначают протяженность местной инвазии в зоне основного опухолевого узла, буквой N (nodes) вовлечение в метастатический процесс региональных лимфатических узлов, буквой М (metastases) наличие дистантных гематогенных метастазов. Индексация символа Т, означающая ту или иную стадию (уровень) Внутри органной инвазии первичного опухолевого узла, имеет отличия, специфичные для разных органов. Общие принципы: n Тx опухоль не обнаруживается; n Тo инвазивного процесса нет, но может быть доброкачественная опухоль; n Tis внутриэпителиальная форма рака – карциномы in situ (рака "на месте"), возникающего в толще эпителия без прорастания через базальную мембрану, т. е. без главного признака злокачественности инвазии; n Т 1 опухолевая инвазия в толщу слизистой оболочки и подслизистого слоя трубчатых и полых органов; n Т 2 З инвазия в /через мышечные слои; n Т 4 прорастание сквозь стенку органа.

Несколько иная индексация принята в отношении букв N и М: n n n No нет метастазов в регионарных лимфатических узлах; N 1, N 2 или NЗ один, два или три лимфогенных метастаза (или же: поражены первый, второй или третий уровни регионарных коллекторов); Мo нет гематогенных метастазов; М 1(печ) или М 2(лег) один метастаз в печени или два в легких, М 1(печ), 2 (лег) один метастаз в печени и два в легких одновременно.

Эпителиальные опухоли n n n При характеристике эпителиальных опухолей выделяют два групповых признака: наличие в большинстве опухолей четкой границы между комплексами (пластами) паренхимы и стромой; возможность озлокачествления (малигнизации) многих доброкачественных эпителиальных опухолей. Доброкачественные опухоли из эпителия Папилломы, развивающиеся из покровного эпителия, возникают на коже, в выстилке мочевых и дыхательных путей, полости рта, пищевода, влагалища. Макроскопически они представляют собой ворсинчатую или сосочковую, обычно подвижную опухоль, растущую на широком основании или тонкой ножке

n Микроскопически для папиллом характерна триада признаков, отражающих тканевый атипизм: - сосочковое строение (в каждом сосочке имеется стромальный фиброваскулярный стержень, покрытый опухолевой паренхимой, т. е. гиперплазированным эпителием); избыточная функция эпителия ворсин (например, гиперкератоз в папилломах кожи); погружной экспансивный рост эпителия в основании опухоли (например, акантоз в папилломах кожи).

n n n Аденомы развиваются из железистого эпителия и возникают в тех трубчатых и полых органах, слизистая оболочка которых содержит множество мелких желез, а также в органах, паренхима которых целиком построена из эпителия (печень, почки, различные железистые органы). В зависимости от конфигурации и размеров концевых железистых трубок, составляющих паренхиму новообразования и подверженных тканевому атипизму, различают трабекулярную, тубулярную, альвеолярную, кистозную (цистаденому) аденомы. При локализации экзофитном росте, например в толстой кишке, такие опухоли называют железистыми полипами. В некоторых органах, например в молочной железе, встречаются варианты аденом с хорошо развитой стромой фuброаденомы.

Slide 8. 2

n n n Макроскопически трабекулярная, тубулярная и альвеолярная аденомы представляют собой ограниченные, округлые узлы умеренной плотности. На разрезе альвеолярная аденома нередко имеет мелкоячеистую структуру; цистоденома тонкостенная киста, которая часто бывает заполнена полупрозрачной жидкостью и может иметь сосочки на внутренней поверхности (сосочковая цистаденома). Железистый полип пищеварительной трубки имеет вид экзофитной пальцевидной или ворсинчатой опухоли, растущей на ножке либо широком основании, а фиброаденома плотный, округлый, подвижный, хорошо ограниченный узел, серовато белого цвета на разрезе.

Slide 8. 1

Slide 8. 6

Slide 8. 13

n n n Микроскопически при трабекулярной, тубулярной и альвеолярной аденомах паренхима опухоли представлена сильно измененными железистыми структурами, принимающими вид соответственно трабекул, вытянутых трубок и мелких мешочков. Цистаденома имеет одну или несколько кистозно растянутых концевых желез, в просвет которых вдаются эпителиальные сосочки. Железистый (аденоматозный) полип ворсинчатого строения отличается от папилломы тем, что ворсины "одеты" эпителием железистого типа (часто с бокаловидными клетками), а также наличием в стромальных стержнях ворсин многочисленных железистых комплексов. В фиброаденоме строма значительно преобладает над железистой паренхимой, формирующей различные по форме структуры.

n n n В паренхиме папиллом и аденом, как и в эпителии, не пораженном опухолью, могут обнаруживаться участки дисплазии. Это варьирующие по степени выраженности внутриэпителиальные нарушения дифференцировки, не достигающие уровня озлокачествления (малигнизации). При слабо выраженной дисплазии эпителиальные клетки начинают терять свою нормальную ориентацию в архитектонике покровного или железистого комплекса. Намечаются признаки клеточного атипизма и полиморфизма, часто бывает гиперплазия этих клеток. В многослойных эпителиях все эти процессы начинаются в базальных отделах и сопровождаются исчезновением границы между указанными отделами и промежуточной зоной. В однослойных эпителиях желез, например в слизистой оболочке пищеварительного тракта, часто имеются элонгация ядер клеток и очаговая гиперплазия последних, приводящая к многорядно многослойному строению эпителия в таких очагах. При сильно выраженной дисплазии отмеченные изменения выражены больше и могут приближаться к уровню карциномы in sitи. Многослойный эпителий может терять зональное строение и приобретать "анархию архитектоники". Клетки, типичные для базального слоя, встречаются в более поверхностных слоях эпителия. Фигуры митозов отмечаются в промежуточных и даже поверхностных слоях. В железистых структурах аденом по мере прогрессирования дисплазии происходит разрастание желез, в которых наряду с увеличивающимся клеточным атипизмом и полиморфизмом прогрессирует стратификация, т. е. превращение эпителия в многорядно многослойный пласт.

Slide 8. 19

Злокачественные опухоли из эпителия (карциномы, рак) Существуют различные классификации и системы обозначения карцином: n по (органному) типу эпителия, из которого они возникают (почечно клеточный рак, гепатоцеллюлярный рак, переходно клеточный рак); n по типу дифферона, давшего начало опухолевой паренхиме (В или С клеточная карцинома щитовидной железы; G или D клеточный рак поджелудочной железы); n по гистологическому строению и степени развития паренхимы, независимо от тканевого источника. Чаще всего используется последний принцип. При этом различают плоскоклеточный рак, аденокарциному, солидный рак, скирр и анапластическую карциному.

Slide 8. 17

Плоскоклеточный рак развивается в органах, в которых в норме есть многослойный плоский эпителий (влагалищная порция шейки матки, кожа, пищевод и др. ); возможна метаплазия (бронхи, мочевой пузырь). Микроскопически n при высокой степени дифференцировки n (эпидермоидный рак) в пластах раковой паренхимы клеточный атипизм и полиморфизм выражены не значительно. Во многих из них прослеживается определенная зональность строения, напоминающая базальный, шиповатый и зернистый слои эпидермиса. В центре некоторых раковых пластов встречаются гомогенные и/или слоистые эозинофильные массы кератогиалина ("жемчужины"). При низкой степени дифференцировки уровень клеточного атипизма и полиморфизма высок, зональное строение раковых пластов почти не встречается, мелкие "жемчужины" чаще отсутствуют.

Slide 8. 11

Slide 8. 10

Аденокарцинома (железистый рак) возникает в органах, в которых в норме есть железистый эпителий (предстательная железа, толстая кишка, желудок, молочная железа и др. ); возможна метаплазия (органы мочевыводящего тракта). Микроскопически При высокой степени дифференцировки раковый эпителий формирует инвазивные железистые структуры, в которых многие клетки, несмотря на слабовыраженный атипизм и полиморфизм, напоминают свои нормальные аналоги (например, каемчатые энтероциты, бокаловидные клетки в аденокарциноме толстой кишки). В просвете таких железистых структур может находиться соответствующий секрет. При низкой степени дифференцировки железистые комплексы могут выглядеть по разному. Если секреция слизи в них не выражена, то обычно увеличиваются не размеры, а число этих комплексов. Уровень клеточного атипизма и полиморфизма эпителиоцитов высок. В других случаях железистые структуры могут значительно расширяться и переполняться слизью ("озера слизи"). Такую форму называют слизистым или коллоидным раком. Нередко по соседству с "озерами слизи" встречаются перстневидные клетки, заполненные вакуолями слизи, с ядром, оттесненным к плазмолемме. Есть вариант низко дифференцированной аденокарциномы, в которой "озера слизи" отсутствуют, но указанных клеток много. Его называют перстневидно-клеточным раком.

Slide 8. 7

n Умеренно - и низкодифференцированные карциномы локализуются в паренхиме, которая не имеет четкого направления дифференцировки в сторону плоскоклеточного рака или аденокарциномы. Такая раковая паренхима может представлять собой пласты злокачественного эпителия с выраженным атипизмом и полиморфизмом клеток без каких либо их зонального расположения и просвета в центре пласта. Такие формы нередко обозначают по соотношению площадей, занимаемых паренхимой и стромой. Если в опухолевом узле много массивных пластов паренхимы, а стромы относительно мало, то это медуллярный, солидный или мягкий рак. n Если же преобладает строма, то это скирр, твердый или фиброзный рак.

n Анаплазия самая низкая степень гистологической дифференцировки в карциномах, которая выражается в утрате раковым эпителием способности формировать какой либо пласт или комплекс. При этом клетки анапластического рака с максимально выраженными атипизмом и полиморфизмом растут беспорядочно или мелкими группами. Их эпителиальное происхождение приходится часто определять с помощью дополнительных окрасок на мукополисахариды и другие субстанции.

n n n В покровном и железистом эпителиях многих органов пищеварительной, дыхательной и мочеполовой систем содержатся диффузно рассеянные нейроэндокринные клетки (апудоциты). В их цитоплазме специализированные гранулы вырабатывают тот или иной биогенный амин либо полипептидный гормональный продукт. Опухолевая трансформация может затрагивать апудоциты, не поражая при этом соседние эпителиоциты. Развиваются карциноиды, паренхима которых формирует четко ограниченные трабекулярные или солидные комплексы, похожие на пласты солидного рака. Карциноиды могут продуцировать большое количество какого либо гормона, например серотонина (карциноидный синдром). Чаще всего такие опухоли развиваются в аппендиксе, желудке и легком. Обычно они доброкачественные, но иногда возникает и малигнизация.
9-ОПУХОЛИ 3 курс.ppt